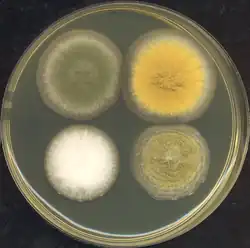

Aspergillus
| Aspergillus | |
|---|---|
| |
| Conidial head of Aspergillus niger | |
| Scientific classification | |
| Kingdom: | Fungi |
| Division: | Ascomycota |
| Class: | Eurotiomycetes |
| Order: | Eurotiales |
| Family: | Aspergillaceae |
| Genus: | Micheli ex Haller (1768) |
| Species | |
| Synonyms[1] | |
|
List
| |
Aspergillus (/ˌæspərˈdʒɪləs/) is a genus consisting of several hundred mold species found in various climates worldwide.
Aspergillus was first catalogued in 1729 by the Italian priest and biologist Pier Antonio Micheli. Viewing the fungi under a microscope, Micheli was reminded of the shape of an aspergillum (holy water sprinkler), from Latin spargere (to sprinkle), and named the genus accordingly.[2][3] Aspergillum is an asexual spore-forming structure common to all Aspergillus species; around one-third of species are also known to have a sexual stage.[4] While some species of Aspergillus are known to cause fungal infections, others are of commercial importance.
Taxonomy
Species
In March 2010, Aspergillus covered 837 species of fungi.[5] Notable species placed in Aspergillus include:
- Aspergillus flavus is a notable plant pathogen impacting crop yields and a common cause of aspergillosis.
- Aspergillus fumigatus is the most common cause of aspergillosis in individuals with an immunodeficiency.
- Aspergillus nidulans has seen heavy use as research organism in cell biology.
- Aspergillus niger is used in the chemical industry for a variety of applications, while also being a known food contaminant and a possible pathogen to humans.
- Aspergillus oryzae and A. sojae are used in East Asian cuisine in the production of sake, soy sauce and other fermented food products.
- Aspergillus terreus is used in the production of organic acids but can also cause opportunistic infections in humans.
Inner taxonomy
The expansive genus Aspergillosis is currently divided into six subgenera of which many are further split into a total of 27 sections.[6]
- Subgenus Circumdati, divided in 10 sections. Linked to former teleomorphic genera Petromyces, Neopetromyces and Fennellia.
- Subgenus Nidulantes, divided in 9 sections. Linked to former teleomorphic genus Emericella.
- Subgenus Fumigati, divided in 4 sections. Linked to former teleomorphic genus Neocarpenteles, Neosartorya and Dichotomomyces.
- Subgenus Aspergillus, divided in 2 sections. Linked to former teleomorphic genus Eurotium.
- Subgenus and section Cremei. Linked to former teleomorphic genus Chaetosartorya and Cristaspora
- Subgenus and section Polypaecilum. Includes former genera Polypaecilum and Phialosimplex.
The linkage to former teleomorphic genera derive from Samson et al. (2014).[7] The current division is based on Houbracken et al. (2020), which also notes that the former teleomorphic genera are now understood as morphotypes: eurotium-type, neosartorya-type, emericella-type, petromyces-type, chaetosartorya-type, fennellia-type and neopetromyces-type.[6]
Growth and distribution
Aspergillus is defined as a group of conidial fungi—that is, fungi in an asexual state. Some of them, however, are known to have a teleomorph (sexual state) in the Ascomycota. With DNA evidence, all members of the genus Aspergillus are members of the phylum Ascomycota.
Members of the genus possess the ability to grow where a high osmotic pressure exists (high concentration of sugar, salt, etc.). Aspergillus species are highly aerobic and are found in almost all oxygen-rich environments, where they commonly grow as molds on the surface of a substrate, as a result of the high oxygen tension. Commonly, fungi grow on carbon-rich substrates like monosaccharides (such as glucose) and polysaccharides (such as amylose). Aspergillus species are common contaminants of starchy foods (such as bread and potatoes), and grow in or on many plants and trees.
In addition to growth on carbon sources, many species of Aspergillus demonstrate oligotrophy where they are capable of growing in nutrient-depleted environments, or environments with a complete lack of key nutrients. Aspergillus niger is a prime example of this; it can be found growing on damp walls, as a major component of mildew.
Several species of Aspergillus, including A. niger and A. fumigatus, will readily colonise buildings,[8] favouring warm and damp or humid areas such as bathrooms and around window frames.[9]
Aspergillus are found in millions of pillows.[10]
Commercial importance

_-Osterloh-_-Brendel_10f-.jpg)
Species of Aspergillus are important medically and commercially. Some species can cause infection in humans and other animals. Some infections found in animals have been studied for years, while other species found in animals have been described as new and specific to the investigated disease, and others have been known as names already in use for organisms such as saprophytes. More than 60 Aspergillus species are medically relevant pathogens.[11] For humans, a range of diseases such as infection to the external ear, skin lesions, and ulcers classed as mycetomas are found.
Other species are important in commercial microbial fermentations. For example, alcoholic beverages such as Japanese sake are often made from rice or other starchy ingredients (like manioc), rather than from grapes or malted barley. Typical microorganisms used to make alcohol, such as yeasts of the genus Saccharomyces, cannot ferment these starches. Therefore, koji mold such as Aspergillus oryzae is used to first break down the starches into simpler sugars.[12]
Members of the genus are also sources of natural products that can be used in the development of medications to treat human disease.[13] Aspergillus spp. are known to produce anthraquinone which has commercial importance due to its antibacterial and antifungal properties.[14]
Perhaps the largest application of Aspergillus niger is as the major source of citric acid; this organism accounts for over 99% of global citric acid production, or more than 1.4 million tonnes (>1.5 million US tons) per year. A. niger is also commonly used for the production of native and foreign enzymes, including glucose oxidase, lysozyme, and lactase.[15] In these instances, the culture is rarely grown on a solid substrate, although this is still common practice in Japan, but is more often grown as a submerged culture in a bioreactor. In this way, the most important parameters can be strictly controlled, and maximal productivity can be achieved. This process also makes it far easier to separate the chemical or enzyme of importance from the medium, and is therefore far more cost-effective.
Research

A. nidulans (Emericella nidulans) has been used as a research organism for many years and was used by Guido Pontecorvo to demonstrate parasexuality in fungi. Recently, A. nidulans was one of the pioneering organisms to have its genome sequenced by researchers at the Broad Institute. As of 2008, a further seven Aspergillus species have had their genomes sequenced: the industrially useful A. niger (two strains), A. oryzae, and A. terreus, and the pathogens A. clavatus, A. fischerianus (Neosartorya fischeri), A. flavus, and A. fumigatus (two strains).[16] A. fischerianus is hardly ever pathogenic, but is very closely related to the common pathogen A. fumigatus; it was sequenced in part to better understand A. fumigatus pathogenicity.[17]
Sexual reproduction
Of the 250 species of aspergilli, about 64% have no known sexual state.[18] However, many of these species likely have an as yet unidentified sexual stage.[18] Sexual reproduction occurs in two fundamentally different ways in fungi. These are outcrossing (in heterothallic fungi) in which two different individuals contribute nuclei, and self-fertilization or selfing (in homothallic fungi) in which both nuclei are derived from the same individual. In recent years, sexual cycles have been discovered in numerous species previously thought to be asexual. These discoveries reflect recent experimental focus on species of particular relevance to humans.
A. fumigatus is the most common species to cause disease in immunodeficient humans. In 2009, A. fumigatus was shown to have a heterothallic, fully functional sexual cycle.[19] Isolates of complementary mating types are required for sex to occur.
A. flavus is the major producer of carcinogenic aflatoxins in crops worldwide. It is also an opportunistic human and animal pathogen, causing aspergillosis in immunocompromised individuals. In 2009, a sexual state of this heterothallic fungus was found to arise when strains of opposite mating types were cultured together under appropriate conditions.[20]
A. lentulus is an opportunistic human pathogen that causes invasive aspergillosis with high mortality rates. In 2013, A. lentulus was found to have a heterothallic functional sexual breeding system.[21]
A. terreus is commonly used in industry to produce important organic acids and enzymes, and was the initial source for the cholesterol-lowering drug lovastatin. In 2013, A. terreus was found to be capable of sexual reproduction when strains of opposite mating types were crossed under appropriate culture conditions.[22]
These findings with Aspergillus species are consistent with accumulating evidence, from studies of other eukaryotic species, that sex was likely present in the common ancestor of all eukaryotes.[23][24]
A. nidulans, a homothallic fungus, is capable of self-fertilization. Selfing involves activation of the same mating pathways characteristic of sex in outcrossing species, i.e. self-fertilization does not bypass required pathways for outcrossing sex, but instead requires activation of these pathways within a single individual.[25]
Among those Aspergillus species that exhibit a sexual cycle, the overwhelming majority in nature are homothallic (self-fertilizing).[26] This observation suggests Aspergillus species can generally maintain sex though little genetic variability is produced by homothallic self-fertilization. A. fumigatus, a heterothallic (outcrossing) fungus that occurs in areas with widely different climates and environments, also displays little genetic variability either within geographic regions or on a global scale,[27] again suggesting sex, in this case outcrossing sex, can be maintained even when little genetic variability is produced.
Genomics
The simultaneous publication of three Aspergillus genome manuscripts in Nature in December 2005 established the genus as the leading filamentous fungal genus for comparative genomic studies. Like most major genome projects, these efforts were collaborations between a large sequencing centre and the respective community of scientists. For example, the Institute for Genome Research (TIGR) worked with the A. fumigatus community. A. nidulans was sequenced at the Broad Institute. A. oryzae was sequenced in Japan at the National Institute of Advanced Industrial Science and Technology. The Joint Genome Institute of the Department of Energy has released sequence data for a citric acid-producing strain of A. niger. TIGR, now renamed the J. Craig Venter Institute, is currently spearheading a project on the A. flavus genome.[28]
Aspergillus is characterized by high levels of genetic diversity and, using protostome divergence as a scale, is as diverse as the Vertebrates phylum although both inter and intra-specific genome structure is relatively plastic.[29] The genomes of some Aspergillus species, such as A. flavus and A. oryzae, are more rich and around 20% larger than others, such as A. nidulans and A. fumigatus. Several mechanisms could explain this difference, although the combination of segmental duplication, genome duplication, and horizontal gene transfer acting in a piecemeal fashion is well-supported.[30]
Genome sizes for sequenced species of Aspergillus range from about 29.3 Mb for A. fumigatus to 37.1 Mb for A. oryzae, while the numbers of predicted genes vary from about 9926 for A. fumigatus to about 12,071 for A. oryzae. The genome size of an enzyme-producing strain of A. niger is of intermediate size at 33.9 Mb.[3]
Pathogens
Some Aspergillus species cause serious disease in humans and animals. The most common pathogenic species are A. fumigatus and A. flavus, which produces aflatoxin which is both a toxin and a carcinogen, and which can contaminate foods such as nuts. The most common species causing allergic disease are A. fumigatus and A. clavatus. Other species are important as agricultural pathogens. Aspergillus spp. cause disease on many grain crops, especially maize, and some variants synthesize mycotoxins, including aflatoxin. Aspergillus can cause neonatal infections.[31]
A. fumigatus (the most common species) infections are primary pulmonary infections and can potentially become a rapidly necrotizing pneumonia with a potential to disseminate. The organism can be differentiated from other common mold infections based on the fact that it takes on a mold form both in the environment and in the host (unlike Candida albicans which is a dimorphic mold in the environment and a yeast in the body).
Aspergillosis

Aspergillosis is the group of diseases caused by Aspergillus. The most common species among paranasal sinus infections associated with aspergillosis is A. fumigatus.[32] The symptoms include fever, cough, chest pain, or breathlessness, which also occur in many other illnesses, so diagnosis can be difficult. Usually, only patients with already weakened immune systems or who suffer other lung conditions are susceptible.
In humans, the major forms of disease are:[33][34]
- Acute invasive aspergillosis, a form that grows into surrounding tissue, more common in those with weakened immune systems such as AIDS or chemotherapy patients
- Allergic bronchopulmonary aspergillosis, which affects patients with respiratory diseases such as asthma, cystic fibrosis, and sinusitis
- Aspergilloma, a "fungus ball" that can form within cavities such as the lung
- Disseminated invasive aspergillosis, an infection spread widely through the body
Fungal infections from Aspergillus spores remain one theory of sickness and untimely death of some early Egyptologists and tomb explorers. Ancient spores which grew on the remains of food offerings and mummies sealed in tombs and chambers may have been blown around and inhaled by the excavators, ultimately linked to the notion of the curse of the pharaohs.[35]
Aspergillosis of the air passages is also frequently reported in birds, and certain species of Aspergillus have been known to infect insects.[11]
Most people inhale Aspergillus into their lungs everyday,[36] but generally only the immuno-compromised become sick with aspergillosis.[36]
See also
References
- ^ "Synonymy. Current Name: Aspergillus P. Micheli ex Haller, Hist. stirp. Helv. (Bernae) 3: 113 (1768)". Species Fungorum. Retrieved 10 October 2023.
- ^ Andrade-Filho Jde S, Pena GP (September–October 2010). "Analogies in medicine: fungus and liturgy". Rev Inst Med Trop Sao Paulo. 52 (5): 288. doi:10.1590/s0036-46652010000500014. PMID 21049237.
- ^ a b Bennett JW (2010). "An Overview of the Genus Aspergillus". Aspergillus: Molecular Biology and Genomics. Caister Academic Press. ISBN 978-1-904455-53-0.
- ^ Geiser DM (2009). "Sexual structures in Aspergillus: morphology, importance and genomics". Medical Mycology. 47. 47 (Suppl 1): S21-6. doi:10.1080/13693780802139859. PMID 18608901.
- ^ Hawksworth DL (April 2011). "Naming Aspergillus species: progress towards one name for each species". Medical Mycology. 49 Suppl 1 (S1): S70-6. doi:10.3109/13693786.2010.504753. PMID 20718610.
- ^ a b Houbraken J, Kocsubé S, Visagie CM, Yulmaz N, Wang XC, Meijer M, Kraak B, Hubka V, Bensch K, Samson RA, Frisvad JC (2020). "Classification of Aspergillus, Penicillium, Talaromyces and related genera (Eurotiales): An overview of families, genera, subgenera, sections, series and species". Studies in Mycology. 95: 5–169. doi:10.1016/j.simyco.2020.05.002. PMC 7426331. PMID 32855739.
- ^ Samson, RA; Visagie, CM; Houbraken, J; Hong, SB; Hubka, V; Klaassen, CHW; Perrone, G; Seifert, KA; Susca, A; Tanney, JB; Varga, J; Kocsubé, S; Szigeti, G; Yaguchi, T; Frisvad, JC (June 2014). "Phylogeny, identification and nomenclature of the genus Aspergillus". Studies in Mycology. 78: 141–173. doi:10.1016/j.simyco.2014.07.004. PMC 4260807. PMID 25492982.
- ^ Latgé JP (April 1999). "Aspergillus fumigatus and aspergillosis". Clinical Microbiology Reviews. 12 (2): 310–50. doi:10.1128/CMR.12.2.310. PMC 88920. PMID 10194462.
- ^ "What are fungal spores?". University of Worcester. Retrieved 6 August 2019.
- ^ "Pillows: A Hot Bed Of Fungal Spores". Science Daily. Archived from the original on 2017-10-08. Retrieved 2017-05-08.
- ^ a b Thom C, Church M (1926). The Aspergilli. Baltimore: The Williams & Wilkins Company.
- ^ Spiegel A (April 8, 2014). "Are You Using The Right Soy Sauce? Here's How To Find Out". The Huffington Post. Archived from the original on 2017-08-06. Retrieved 2017-07-29.
...to make soy sauce, first you add aspergillus mold to the soy beans and grains to produce a mixture called koji.
- ^ US 6069146, Fenical, William; Jensen, Paul R. & Cheng, Xing C., "Halimide, a cytotoxic marine natural product, and derivatives thereof", published 2000-05-30, assigned to The Regents of the University of California
- ^ Toma, Maria Afroz; Nazir, K. H. M. Nazmul Hussain; Mahmud, Md Muket; Mishra, Pravin; Ali, Md Kowser; Kabir, Ajran; Shahid, Md Ahosanul Haque; Siddique, Mahbubul Pratik; Alim, Md Abdul (2021). "Isolation and Identification of Natural Colorant Producing Soil-Borne Aspergillus niger from Bangladesh and Extraction of the Pigment". Foods. 10 (6): 1280. doi:10.3390/foods10061280. PMC 8227025. PMID 34205202.
- ^ "GRAS Notification for Acid Lactase from Aspergillus oryzae Expressed in Aspergillus niger". Food and Drug Administration. Archived from the original on 2016-03-23. Retrieved 2016-03-17. Section 2.
- ^ Wortman JR, Gilsenan JM, Joardar V, Deegan J, Clutterbuck J, Andersen MR, et al. (March 2009). "The 2008 update of the Aspergillus nidulans genome annotation: a community effort". Fungal Genetics and Biology. 46. 46 Suppl 1 (1): S2-13. doi:10.1016/j.fgb.2008.12.003. PMC 2826280. PMID 19146970.
- ^ "Descriptions – Aspergillus Comparative". Broad Institute. Archived from the original on 22 November 2009. Retrieved 2009-10-15.
- ^ a b Dyer PS, O'Gorman CM (December 2011). "A fungal sexual revolution: Aspergillus and Penicillium show the way". Current Opinion in Microbiology. 14 (6): 649–54. doi:10.1016/j.mib.2011.10.001. PMID 22032932.
- ^ O'Gorman CM, Fuller H, Dyer PS (January 2009). "Discovery of a sexual cycle in the opportunistic fungal pathogen Aspergillus fumigatus". Nature. 457 (7228): 471–4. Bibcode:2009Natur.457..471O. doi:10.1038/nature07528. PMID 19043401. S2CID 4371721.
- ^ Horn BW, Moore GG, Carbone I (2009). "Sexual reproduction in Aspergillus flavus". Mycologia. 101 (3): 423–9. doi:10.3852/09-011. PMID 19537215. S2CID 20648447.
- ^ Swilaiman SS, O'Gorman CM, Balajee SA, Dyer PS (July 2013). "Discovery of a sexual cycle in Aspergillus lentulus, a close relative of A. fumigatus". Eukaryotic Cell. 12 (7): 962–9. doi:10.1128/EC.00040-13. PMC 3697472. PMID 23650087.
- ^ Arabatzis M, Velegraki A (2013). "Sexual reproduction in the opportunistic human pathogen Aspergillus terreus". Mycologia. 105 (1): 71–9. doi:10.3852/11-426. PMID 23074177. S2CID 9584227.
- ^ Malik SB, Pightling AW, Stefaniak LM, Schurko AM, Logsdon JM (August 2007). "An expanded inventory of conserved meiotic genes provides evidence for sex in Trichomonas vaginalis". PLOS ONE. 3 (8): e2879. Bibcode:2008PLoSO...3.2879M. doi:10.1371/journal.pone.0002879. PMC 2488364. PMID 18663385.
- ^ Heitman J, Sun S, James TY (2013). "Evolution of fungal sexual reproduction". Mycologia. 105 (1): 1–27. doi:10.3852/12-253. PMID 23099518. S2CID 18167947.
- ^ Paoletti M, Seymour FA, Alcocer MJ, Kaur N, Calvo AM, Archer DB, Dyer PS (August 2007). "Mating type and the genetic basis of self-fertility in the model fungus Aspergillus nidulans". Current Biology. 17 (16): 1384–9. Bibcode:2007CBio...17.1384P. doi:10.1016/j.cub.2007.07.012. PMID 17669651. S2CID 17068935.
- ^ Dyer PS, O'Gorman CM (January 2012). "Sexual development and cryptic sexuality in fungi: insights from Aspergillus species". FEMS Microbiology Reviews. 36 (1): 165–92. doi:10.1111/j.1574-6976.2011.00308.x. PMID 22091779.
- ^ Rydholm C, Szakacs G, Lutzoni F (April 2006). "Low genetic variation and no detectable population structure in aspergillus fumigatus compared to closely related Neosartorya species". Eukaryotic Cell. 5 (4): 650–7. doi:10.1128/EC.5.4.650-657.2006. PMC 1459663. PMID 16607012.
- ^ Machida M, Gomi K, eds. (2010). Aspergillus: Molecular Biology and Genomics. Caister Academic Press. ISBN 978-1-904455-53-0.
- ^ Gibbons JG, Rokas A (January 2013). "The function and evolution of the Aspergillus genome". Trends in Microbiology. 21 (1): 14–22. doi:10.1016/j.tim.2012.09.005. PMC 3534798. PMID 23084572.
- ^ Khaldi N, Wolfe KH (August 2008). Gadagkar S (ed.). "Elusive origins of the extra genes in Aspergillus oryzae". PLOS ONE. 3 (8): e3036. Bibcode:2008PLoSO...3.3036K. doi:10.1371/journal.pone.0003036. PMC 2515630. PMID 18725939.
- ^ Cloherty J (2012). Manual of neonatal care. Philadelphia: Wolters Kluwer Health/Lippincott Williams & Wilkins. ISBN 978-1-60831-777-6; Access provided by the University of Pittsburgh.
{{cite book}}: CS1 maint: postscript (link) - ^ Bozkurt MK, Ozçelik T, Saydam L, Kutluay L (2008). "[A case of isolated aspergillosis of the maxillary sinus]". Kulak Burun Bogaz Ihtisas Dergisi (in Turkish). 18 (1): 53–5. PMID 18443405.
- ^ "Aspergillosis". MedScape. Archived from the original on 2014-02-23. Retrieved 2014-06-29.
- ^ Wilson WR, Sande MA, Drew WL, eds. (2001). Current diagnosis & treatment in infectious diseases. Lange Medical Books/McGraw-Hill.
- ^ Di Paolo N, Guarnieri A, Garosi G, Sacchi G, Mangiarotti AM, Di Paolo M (1994). "Inhaled mycotoxins lead to acute renal failure". Nephrology, Dialysis, Transplantation. 9 (Suppl 4): 116–20. PMID 7800243.
- ^ a b "Aspergillosis | Types of Fungal Diseases | Fungal Diseases | CDC". www.cdc.gov. 2021-05-10. Retrieved 2022-09-02.
Further reading
- Asan A. (February 10, 2015) [2004]. "Aspergillus, Penicillium, and Related Species Reported from Turkey" (PDF). Mycotaxon. 89 (1): 155–7.
- Du C, Lin SK, Koutinas A, Wang R, Dorado P, Webb C (November 2008). "A wheat biorefining strategy based on solid-state fermentation for fermentative production of succinic acid". Bioresource Technology. 99 (17): 8310–5. Bibcode:2008BiTec..99.8310D. doi:10.1016/j.biortech.2008.03.019. PMID 18434138.
- Soltani J (2016). "Secondary Metabolite Diversity of the Genus Aspergillus.". Recent Advances New and Future Developments in Microbial Biotechnology and Bioengineering: Aspergillus System Properties and Applications. pp. 275–292.
- Zirbes JM, Milla CE (June 2008). "Steroid-sparing effect of omalizumab for allergic bronchopulmonary aspergillosis and cystic fibrosis". Pediatric Pulmonology. 43 (6): 607–10. doi:10.1002/ppul.20804. PMID 18433040. S2CID 25806792.
External links
- Aspergillus Comparative Database Comparative genomic resource at the Broad Institute
- Aspergillus Genome Resources (NIH)
- Aspergillus surveillance project at a large tertiary-care hospital. (PDF).
- Central Aspergillus Data Repository
- FungiDB: An integrated functional genomics database for fungi and oomycetes
- Mold and Mildew
- The Aspergillus Genome Database Archived 2021-05-25 at the Wayback Machine
- The Aspergillus/Aspergillosis Website An encyclopedia of Aspergillus for patients, doctors and scientists
- The Fungal Genetics Stock Center Archived 2006-10-01 at the Wayback Machine
